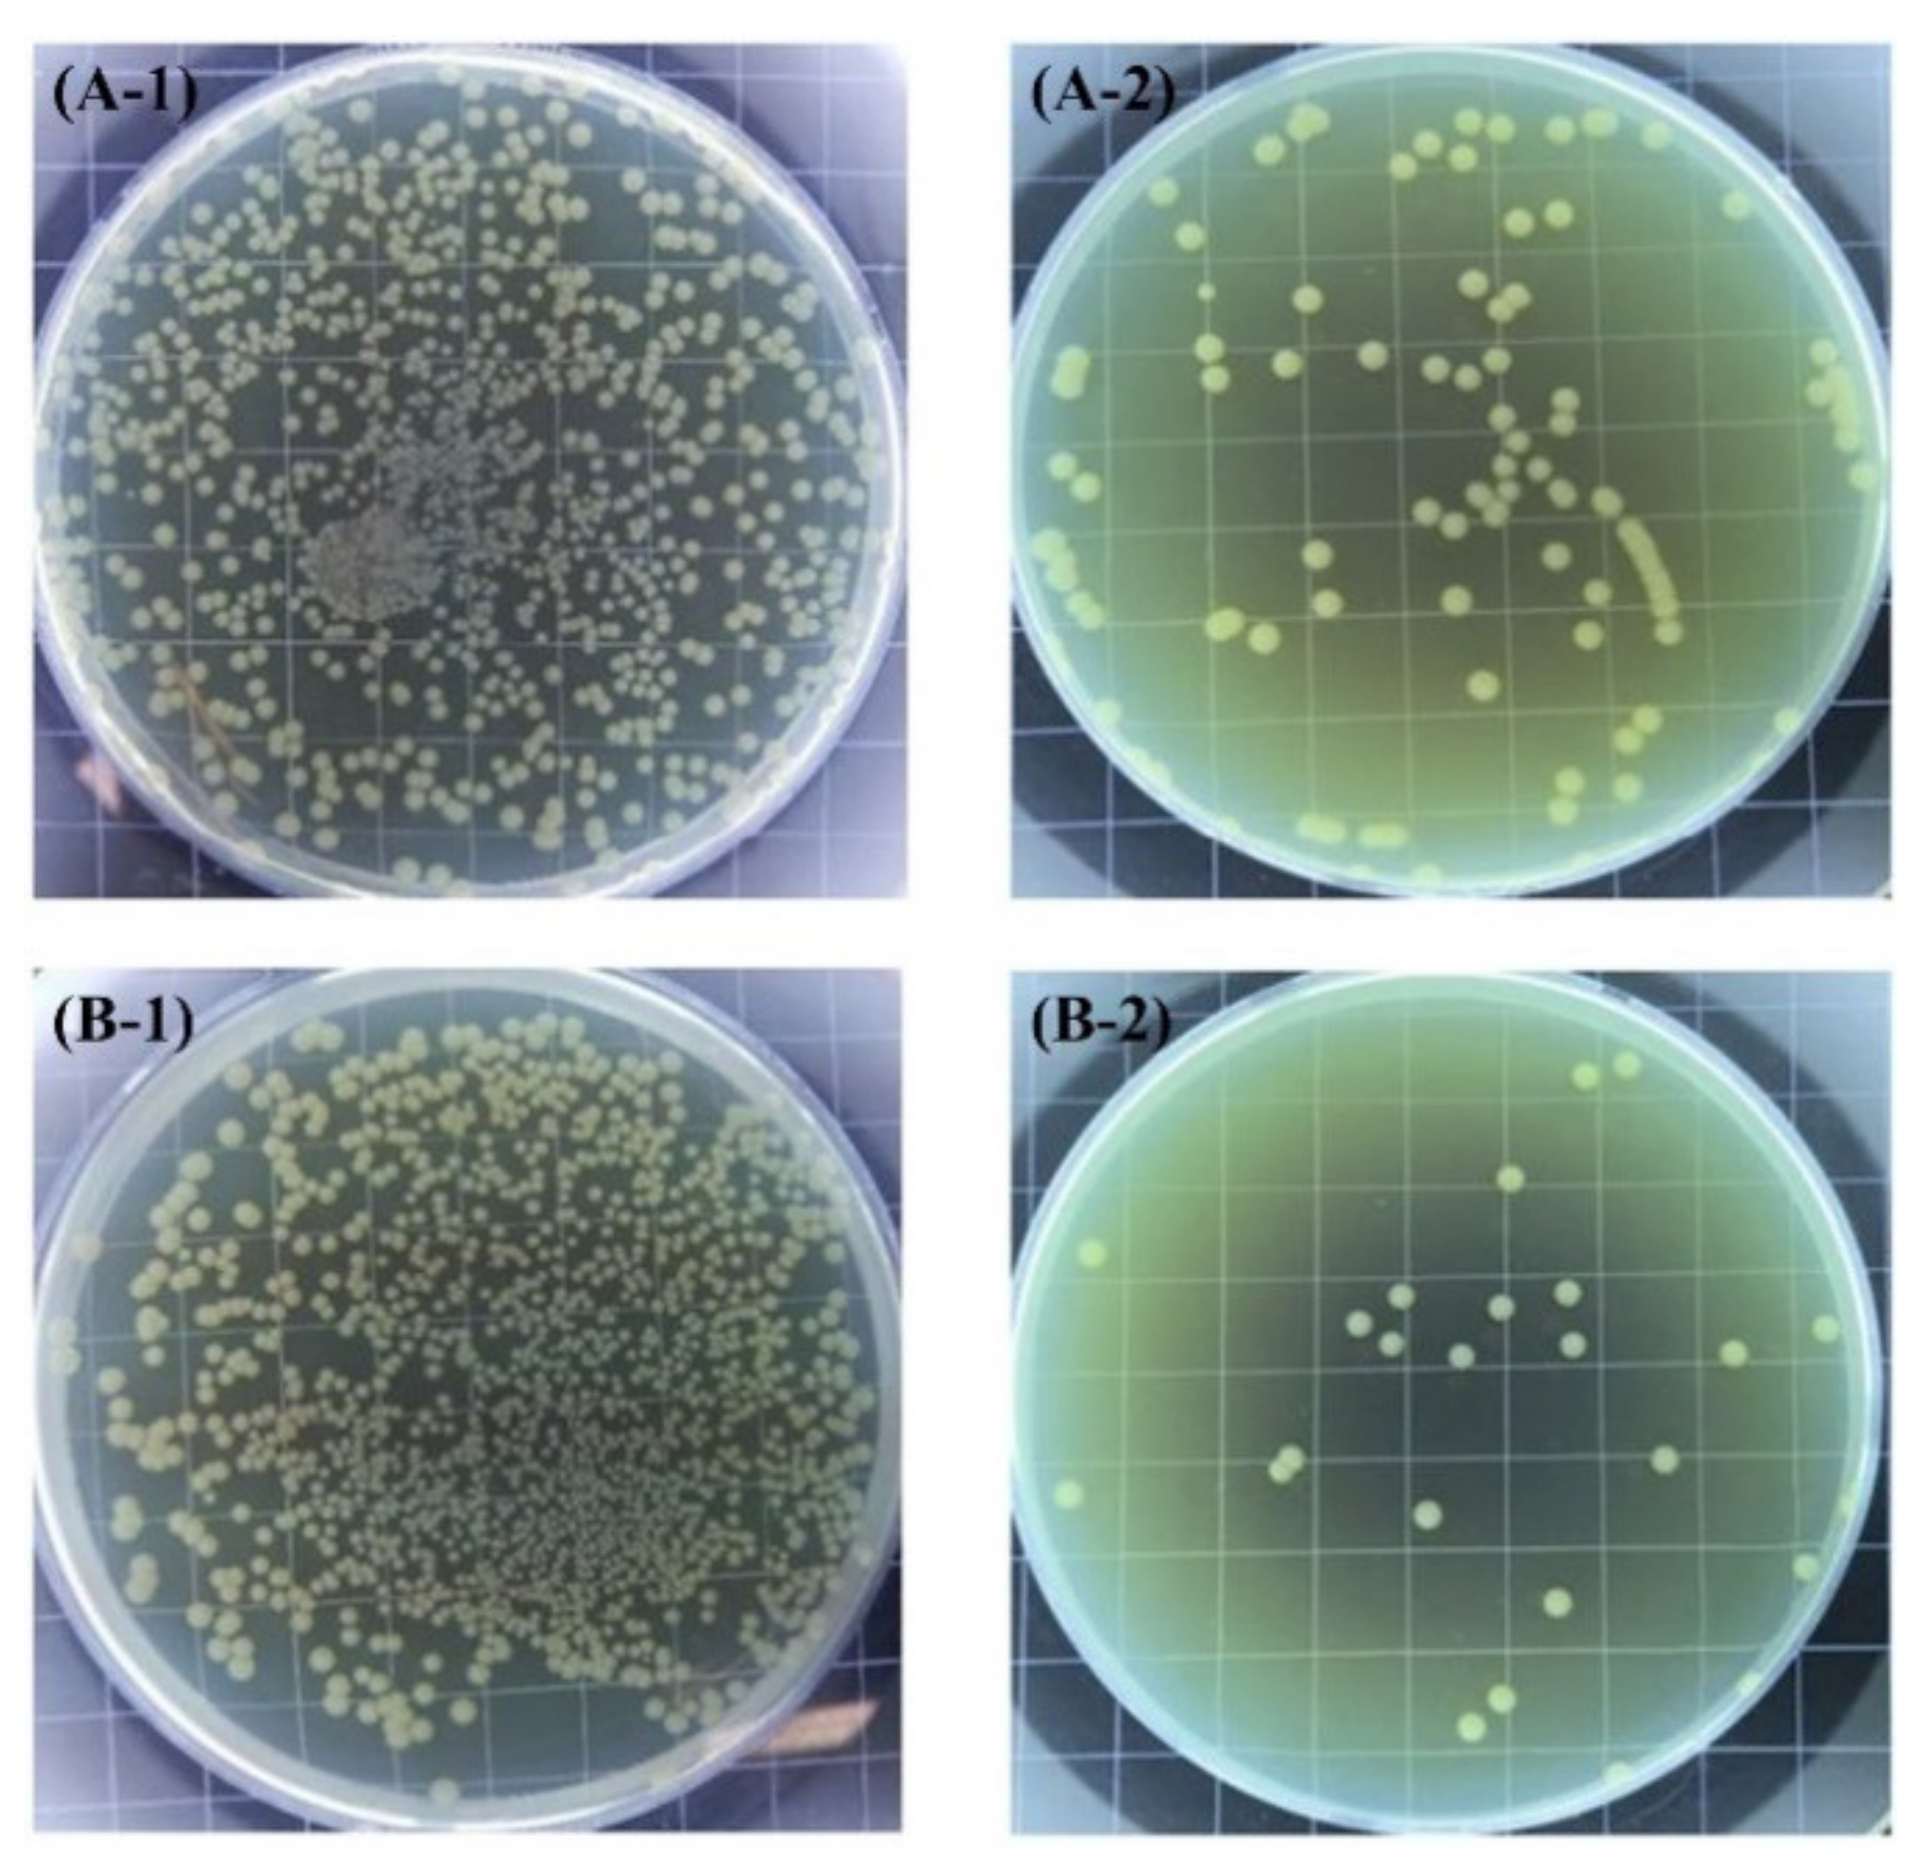
Toxics 10 00035 g006 550

Use of Nanotechnology to Mitigate Biofouling in Stainless Steel Devices Used in Food Processing, Healthcare, and Marine Environments
Abstract
:1. Introduction
- The wide spectrum of nanoparticles available with different mechanisms of biocidal action allows them to be used synergistically to inhibit the formation of biofilms and consequently avoid micro and macro fouling [13];
- The controlled release capacity of “smart”/stimuli-responsive nanomaterials. Mesoporous silica nanocapsules, layered double hydroxides, halloysite nanotubes, and surface functionalization can increase antifouling activity time by up to one year through the controlled release of biocides. Controlled release can also reduce the toxicity of biocides relative to their application in free form. Furthermore, it was demonstrated that some of these “smart” nanomaterials exhibit eco-friendly properties since the controlled release capacity ensures a significant reduction in toxicity and environmental hazards compared with the conventional booster biocides [14,15].
2. Environments in Which Biofouling Often Occurs
2.1. Marine Environments
2.2. Food Processing
2.3. Devices Used in Human Health Care
3. The Biofouling Process
3.1. Stage 1. Biofilm Formation
3.2. Stage 2. Primary Colonization
3.3. Stage 3. Secondary Colonization (Micro Encrustation)
3.3.1. Marine Environments
3.3.2. Food Processing
3.3.3. Implants and Biomedical Devices
3.4. Stage 4. Tertiary Colonization (Macro Encrustation)
4. Use of Nanotechnology to Mitigate the Biofouling Process on Stainless Steel
- the use of metallic nanoparticles in organic matrix coatings;
- the generation of nano textures on the surface.
4.1. Use of Metallic Nanoparticles in Organic Matrix Coatings

4.2. Generation of Nanotextures on Stainless Steel
5. Nanomaterials with Potential Use to Inhibit Biofouling on Stainless Steel
5.1. Mesoporous Silica Nanocapsules
- Particles can adhere to gills, interfering with filtration/respiration, leading to sublethal effects that ultimately cause the death;
- Particles can adhere to the body surface, affecting mobility which can cause starvation and death;
- Particles can cause a shadowing effect on the microalgae, which can interfere with the photosynthesis process.
5.2. Layered Double Hydroxides
5.3. Halloysite Nanotubes
5.4. Surface Functionalization
6. Conclusions
Author Contributions
Funding
Institutional Review Board Statement
Informed Consent Statement
Data Availability Statement
Acknowledgments
Conflicts of Interest
References
- Dong, B.; Manolache, S.; Somers, E.B.; Lee Wong, A.C.; Denes, F.S. Generation of antifouling layers on stainless steel surfaces by plasma-enhanced crosslinking of polyethylene glycol. J. Appl. Polym. Sci. 2005, 97, 485–497. [Google Scholar] [CrossRef]
- Yebra, D.M.; Kiil, S.; Dam-Johansen, K. Antifouling technology—Past, present and future steps towards efficient and environmentally friendly antifouling coatings. Prog. Org. Coat. 2004, 50, 75–104. [Google Scholar] [CrossRef]
- Costerton, J.W.; Lewandowski, Z.; Caldwell, D.E.; Korber, D.R.; Lappin-Scott, H.M. Microbial biofilms. Annu. Rev. Microbiol. 1995, 49, 711–745. [Google Scholar] [CrossRef] [PubMed]
- Kumar, C.G.; Anand, S.K. Significance of microbial biofilms in food industry: A review. Int. J. Food Microbiol. 1998, 42, 9–27. [Google Scholar] [CrossRef]
- Rascio, V.J.D. Antifouling coatings: Where do we go from here. Corros. Rev. 2000, 18, 133–154. [Google Scholar] [CrossRef]
- Little, B.J.; Lee, J.S. Microbiologically Influenced Corrosion. In Kirk-Othmer Encyclopedia of Chemical Technology; John Willey & Sons, Inc.: Hoboken, NJ, USA, 2009; pp. 1–42. [Google Scholar]
- Hamilton, W.A. Microbially influenced corrosion as a model system for the study of metal microbe interactions: A unifying electron transfer hypothesis. Biofouling 2003, 19, 65–76. [Google Scholar] [CrossRef]
- Koch, G.; Varney, J.; Thompson, N.; Moghissi, O.; Gould, M.; Payer, J. International Measures of Prevention, Application, and Economics of Corrosion Technologies Study; NACE International: Houston, TX, USA, 2016; Volume 216, Available online: http://impact.nace.org/documents/Nace-International-Report.pdf (accessed on 10 November 2021).
- CORDIS. Community Research and Development Information Service. Impact of Biofilm and Bioufouling on Materials and Processes, CORDIS, European Union. Available online: https://cordis.europa.eu/project/id/2306 (accessed on 10 November 2021).
- Morones, J.R.; Elechiguerra, J.L.; Camacho, A.; Holt, K.; Kouri, J.B.; Ramírez, J.T.; Yacaman, M.J. The bactericidal effect of silver nanoparticles. Nanotechnology 2005, 16, 2346–2353. [Google Scholar] [CrossRef] [Green Version]
- Raffi, M.; Mehrwan, S.; Bhatti, T.M.; Akhter, J.I.; Hameed, A.; Yawar, W.; ul Hasan, M.M. Investigations into the antibacterial behavior of copper nanoparticles against Escherichia coli. Ann. Microbiol. 2010, 60, 75–80. [Google Scholar] [CrossRef]
- Cousins, B.G.; Allison, H.E.; Doherty, P.J.; Edwards, C.; Garvey, M.J.; Martin, D.S.; Williams, R.L. Effects of a nanoparticulate silica substrate on cell attachment of Candida albicans. J. Appl. Microbiol. 2007, 102, 757–765. [Google Scholar] [CrossRef]
- Tallósy, S.P.; Janovák, L.; Nagy, E.; Deák, Á.; Juhász, Á.; Csapó, E.; Buzás, N.; Dékány, I. Adhesion and inactivation of Gram-negative and Gram-positive bacteria on photoreactive TiO2/polymer and Ag–TiO2/polymer nanohybrid films. Appl. Surf. Sci. 2016, 371, 139–150. [Google Scholar] [CrossRef] [Green Version]
- Avelelas, F.; Martins, R.; Oliveira, T.; Maia, F.; Malheiro, E.; Soares, A.M.V.M.; Loureiro, S.; Tedim, J. Efficacy and Ecotoxicity of Novel Anti-Fouling Nanomaterials in Target and Non-Target Marine Species. Mar. Biotechnol. 2017, 19, 164–174. [Google Scholar] [CrossRef]
- Gutner-Hoch, E.; Martins, R.; Oliveira, T.; Maia, F.; Soares, A.M.V.M.; Loureiro, S.; Piller, C.; Preiss, I.; Weis, M.; Larroze, S.B.; et al. Antimacrofouling Efficacy of Innovative Inorganic Nanomaterials Loaded with Booster Biocides. J. Mar. Sci. Eng. 2018, 6, 6. [Google Scholar] [CrossRef] [Green Version]
- Dhanak, M.R.; Xiros, N.I. Springer Handbook of Ocean Engineering; Springer: Berlin/Heidelberg/Leipzig, Germany, 2016. [Google Scholar]
- Byron, F. Corrosion Impact of Offshore Platforms, Structures, and Vessels, Materials Performance. Available online: https://www.materialsperformance.com/articles/corrosion-basics/2020/12/corrosion-impact-of-offshore-platforms-structures-and-vessels (accessed on 1 June 2021).
- Melchers, R.E.; Jeffrey, R. Corrosion of long vertical steel strips in the marine tidal zone and implications for ALWC. Corros. Sci. 2012, 65, 26–36. [Google Scholar] [CrossRef]
- Little, B.J.; de Palma, J.T. Chapter 3. Marine Biofouling. In Materials for Marine Systems and Structures: Treatise on Materials Science and Technology; Hasson, D.F., Crowe, C., Eds.; Academic Press Inc.: London, UK, 1988; Volume 28, pp. 90–117. [Google Scholar]
- Relini, G.; Dabini-Oliva, G. Proceedings of the Third International Congress On Marine Corrosion and Fouling, National Bureau of Standards, Gaithersburg, MA, USA, 2–6 October 1972; Northwestern University Press: Evanston, IL, USA, 1972; pp. 757–766. [Google Scholar]
- Huve, P. Étude expérimentale du peuplement de surfaces rocheuses immergées, en Méditerranée occidentale. Comptes Rendus Hebd. Séances L’académie Sci. 1953, 236, 419–422. [Google Scholar]
- Jannasch, H.W.; Eimhjellen, K.; Wirsen, C.; Farmanfarmaian, A. Microbial degradation of organic matter in the deep sea. Science 1971, 171, 672–675. [Google Scholar] [CrossRef]
- Berger, L.R. Enzyme kinetics, microbial respiration, and active transport at increased hydrostatic pressure. Rev. Phys. Chem. Jpn. 1974, 1, 639–642, Special Issue. [Google Scholar]
- Carpentier, B.; Cerf, O. Biofilms and their consequences, with particular reference to hygiene in the food industry. J. Appl. Bacteriol. 1993, 75, 499–511. [Google Scholar] [CrossRef]
- García-Gonzalo, D.; Pagán, R. Influence of environmental factors on bacterial biofilm formation in the food industry: A review. J. Postdr. Res. 2015, 3, 3–13. [Google Scholar] [CrossRef] [Green Version]
- Sanz, M. Multi-Species Biofilms in the Food Industry. Available online: https://www.betelgeux.es/blog/2019/11/08/biofilms-multiespecie-en-la-industria-alimentaria/#:~:text=The%20biofilms%20act%20C3%BAan%20as%20an%20extracellular%20that%20they%20myself%20generate (accessed on 10 November 2021).
- Mariani, C.; Oulahal, N.; Chamba, J.F.; Dubois-Brissonnet, F.; Notz, E.; Briandet, R. Inhibition of Listeria monocytogenes by resident biofilms present on wooden shelves used for cheese ripening. Food Control 2011, 22, 1357–1362. [Google Scholar] [CrossRef]
- Wirtanen, G.; Husmark, U.; Mattila-Sandholm, T. Microbial Evaluation of the Biotransfer Potential from Surfaces with Bacillus Biofilms after Rinsing and Cleaning Procedures in Closed Food-Processing Systems. J. Food Prot. 1996, 59, 727–733. [Google Scholar] [CrossRef]
- An, Y.H.; Friedman, R.J. Concise review of mechanisms of bacterial adhesion to biomaterial surfaces. J. Biomed. Mater. Res. 1998, 43, 338–348. [Google Scholar] [CrossRef]
- Katsikogianni, M.; Missirlis, Y.F. Concise review of mechanisms of bacterial adhesion to biomaterials and of techniques used in estimating bacteria-material interactions. Eur. Cells Mater. 2004, 8, 37–57. [Google Scholar] [CrossRef] [PubMed]
- Morisaki, H.; Tabuchi, H. Bacterial attachment over a wide range of ionic strengths. Colloids Surf. B Biointerfaces 2009, 74, 51–55. [Google Scholar] [CrossRef] [PubMed]
- Chavant, P.; Martinie, B.; Meylheuc, T.; Bellon-Fontaine, M.-N.; Hebraud, M. Listeria monocytogenes LO28: Surface physicochemical properties and ability to form biofilms at different temperatures and growth phases. Appl. Environ. Microbiol. 2002, 68, 728–737. [Google Scholar] [CrossRef] [Green Version]
- Di Ciccio, P.; Vergara, A.; Festino, A.R.; Paludi, D.; Zanardi, E.; Ghidini, S.; Ianieri, A. Biofilm formation by Staphylococcus aureus on food contact surfaces: Relationship with temperature and cell surface hydrophobicity. Food Control 2015, 50, 930–936. [Google Scholar] [CrossRef]
- Garrett, T.R.; Bhakoo, M.; Zhang, Z. Bacterial adhesion and biofilms on surfaces. Prog. Nat. Sci. 2008, 18, 1049–1056. [Google Scholar] [CrossRef]
- Villain-Simonnet, A.; Milas, M.; Rinaudo, M. A new bacterial exopolysaccharide (YAS34). II. Influence of thermal treatments on the conformation and structure. Relation with gelation ability. Int. J. Biol. Macromol. 2000, 27, 77–87. [Google Scholar] [CrossRef]
- Anderson, G.; O’toole, G. Innate and induced resistance mechanisms of bacterial biofilms. In Bacterial Biofilms; Romeo, T., Ed.; Springer: Berlin/Heidelberg, Germany, 2008; pp. 85–105. [Google Scholar]
- Moreno-Castilla, C. Adsorption of organic molecules from aqueous solutions on carbon materials. Carbon 2004, 42, 83–94. [Google Scholar] [CrossRef] [Green Version]
- Trulear, M.G.; Characklis, W.G. Dynamics of Biofilm Processes. J. Water Pollut. Control Fed. 1982, 54, 1288–1301. [Google Scholar]
- LoVetri, K.; Gawande, P.V.; Yakandawala, N.; Madhyastha, S. Biofouling and Anti-Fouling of Medical Devices. In Biofouling: Types, Impact and Anti-Fouling; Chan, J., Wong, S., Eds.; Nova Science Publishers, Incorporated: New York, NY, USA, 2010; pp. 105–127. [Google Scholar]
- Puhakka, E.; Riihimäki, M.; Keiski, R. Fouling mechanisms by ab initio calculations condensation reactions on the rutile (101) surface and adsorption of ions on the Cr2O3 surfaces. In Proceedings of the ECI Symposium Series, Volume RPS: Proceedings of 7th International Conference on Heat Exchanger Fouling and Cleaning VII RP5, Tomar, Portugal, 1–6 July 2007; pp. 300–307. Available online: https://dc.engconfintl.org/heatexchanger2007 (accessed on 10 November 2021).
- Zhang, W.; Ding, W.; Li, Y.-X.; Tam, C.; Bougouffa, S.; Wang, R.; Pei, B.; Chiang, H.; Leung, P.; Lu, Y.; et al. Marine biofilms constitute a bank of hidden microbial diversity and functional potential. Nat. Commun. 2019, 10, 517. [Google Scholar] [CrossRef]
- Ghiya, S. Self-polishing antifoulings. Paintindia 1987, 37, 19–31. [Google Scholar]
- Abarzua, S.; Jakubowski, S. Biotechnological investigation for the prevention of biofouling. I. Biological and biochemical principles for the prevention of biofouling. Mar. Ecol. Prog. Ser. 1995, 123, 301–312. [Google Scholar] [CrossRef]
- Krishnan, M.; Sivanandham, V.; Hans-Uwe, D.; Murugaiah, S.G.; Seeni, P.; Gopalan, S.; Rathinam, A.J. Antifouling assessments on biogenic nanoparticles: A field study from polluted offshore platform. Mar. Pollut. Bull. 2015, 101, 816–825. [Google Scholar] [CrossRef]
- Flemming, H.-C.; Griebe, T.; Schaule, G. Antifouling strategies in technical systems—A short review. Water Sci. Technol. 1996, 34, 517–524. [Google Scholar] [CrossRef]
- Dang, H.; Li, T.; Chen, M.; Huang, G. Cross-ocean distribution of Rhodobacterales bacteria as primary surface colonizers in temperate coastal marine waters. Appl. Environ. Microbiol. 2008, 74, 52–60. [Google Scholar] [CrossRef] [Green Version]
- Furey, P.C.; Liess, A.; Lee, S. Substratum-Associated Microbiota. Water Environ. Res. 2017, 89, 1634–1675. [Google Scholar] [CrossRef]
- Little, B.J.; Lee, J.S.; Ray, R.I. The influence of marine biofilms on corrosion: A concise review. Electrochim. Acta 2008, 54, 2–7. [Google Scholar] [CrossRef]
- Briandet, R.; Meylheuc, T.; Maher, C.; Bellon-Fontaine Marie, N. Listeria monocytogenes Scott A: Cell Surface Charge, Hydrophobicity, and Electron Donor and Acceptor Characteristics under Different Environmental Growth Conditions. Appl. Environ. Microbiol. 1999, 65, 5328–5333. [Google Scholar] [CrossRef] [Green Version]
- Harvey, J.; Keenan, K.P.; Gilmour, A. Assessing biofilm formation by Listeria monocytogenes strains. Food Microbiol. 2007, 24, 380–392. [Google Scholar] [CrossRef]
- Potera, C. Forging a Link Between Biofilms and Disease. Science 1999, 283, 1837–1839. [Google Scholar] [CrossRef]
- Stewart, P.S. Theoretical aspects of antibiotic diffusion into microbial biofilms. Antimicrob. Agents Chemother. 1996, 40, 2517–2522. [Google Scholar] [CrossRef] [PubMed] [Green Version]
- Lami, R. Chapter 3—Quorum Sensing in Marine Biofilms and Environments. In Quorum Sensing; Tommonaro, G., Ed.; Academic Press: Cambridge, MA, USA, 2019; pp. 55–96. [Google Scholar]
- Teo Wendy, Z.W.; Schalock, P.C. Hypersensitivity Reactions to Implanted Metal Devices: Facts and Fictions. J. Investig. Allergol. Clin. Immunol. 2016, 26, 279–294. [Google Scholar] [CrossRef] [PubMed] [Green Version]
- Van der Borden, A.J.; Maathuis, P.G.M.; Engels, E.; Rakhorst, G.; van der Mei, H.C.; Busscher, H.J.; Sharma, P.K. Prevention of pin tract infection in external stainless steel fixator frames using electric current in a goat model. Biomaterials 2007, 28, 2122–2126. [Google Scholar] [CrossRef] [PubMed]
- Habibzadeh, S.; Li, L.; Shum-Tim, D.; Davis, E.C.; Omanovic, S. Electrochemical polishing as a 316L stainless steel surface treatment method: Towards the improvement of biocompatibility. Corros. Sci. 2014, 87, 89–100. [Google Scholar] [CrossRef]
- Dang, H.; Lovell Charles, R. Microbial Surface Colonization and Biofilm Development in Marine Environments. Microbiol. Mol. Biol. Rev. 2016, 80, 91–138. [Google Scholar] [CrossRef] [PubMed] [Green Version]
- Railkin, A.I. Marine Biofouling: Colonization Processes and Defenses; CRC Press: Boca Raton, FL, USA, 2003. [Google Scholar]
- Finlay, J.A.; Callow, M.E.; Ista, L.K.; Lopez, G.P.; Callow, J.A. The Influence of Surface Wettability on the Adhesion Strength of Settled Spores of the Green Alga Enteromorpha and the Diatom Amphora1. Integr. Comp. Biol. 2002, 42, 1116–1122. [Google Scholar] [CrossRef] [PubMed]
- Gebeshuber, I.C.; Stachelberger, H.; Drack, M. Diatom bionanotribology—biological surfaces in relative motion: Their design, friction, adhesion, lubrication and wear. J. Nanosci. Nanotechnol. 2005, 5, 79–87. [Google Scholar] [CrossRef]
- Xu, C.; Zhang, Y.; Cheng, G.; Zhu, W. Localized corrosion behavior of 316L stainless steel in the presence of sulfate-reducing and iron-oxidizing bacteria. Mater. Sci. Eng. A 2007, 443, 235–241. [Google Scholar] [CrossRef]
- Lewandowskiy, Z.; Dickinsony, W.; Leey, W. Electrochemical interactions of biofilms with metal surfaces. Water Sci. Technol. 1997, 36, 295–302. [Google Scholar] [CrossRef]
- Chamritski, I.G.; Burns, G.R.; Webster, B.J.; Laycock, N.J. Effect of Iron-Oxidizing Bacteria on Pitting of Stainless Steel. Corrosion 2004, 60, 658–669. [Google Scholar] [CrossRef]
- Figueroa de Gil, Y.F.; Camero, S.; Prin, J.L.; Réquiz, R. Evaluación de la corrosión inducida por bacteria sulfato reductora en un acero inoxidable 316L. Rev. Latinoam. Metal. Y Mater. 2008, 28, 60–72. [Google Scholar]
- Santander, C. Estudio Experimental de Corrosión en Metales de uso Industrial por Desulfovibrio Desulfuricans; Memory to get a Civil Engineer in Biotechnology degree. Univeridad de Chile, Santiago de Chile. 2008. Available online: https://repositorio.uchile.cl/handle/2250/103133 (accessed on 30 November 2021).
- Emerson, D.; Fleming, E.J.; McBeth, J.M. Iron-Oxidizing Bacteria: An Environmental and Genomic Perspective. Annu. Rev. Microbiol. 2010, 64, 561–583. [Google Scholar] [CrossRef]
- Bixler, G.D.; Bhushan, B. Biofouling: Lessons from nature. Philos. Trans. R. Soc. A Math. Phys. Eng. Sci. 2012, 370, 2381–2417. [Google Scholar] [CrossRef]
- Chen, M.; Yu, Q.; Sun, H. Novel Strategies for the Prevention and Treatment of Biofilm Related Infections. Int. J. Mol. Sci. 2013, 14, 18488–18501. [Google Scholar] [CrossRef] [Green Version]
- Donlan, R.M. Biofilms and device-associated infections. Emerg. Infect. Dis. 2001, 7, 277–281. [Google Scholar] [CrossRef]
- Cao, S.; Wang, J.; Chen, H.; Chen, D. Progress of marine biofouling and antifouling technologies. Chin. Sci. Bull. 2011, 56, 598–612. [Google Scholar] [CrossRef] [Green Version]
- André, C.; Jonsson, P.R.; Lindegarth, M. Predation on settling bivalve larvae by benthic suspension feeders: The role of hydrodynamics and larval behaviour. Mar. Ecol. Prog. Ser. 1993, 97, 183–192. [Google Scholar] [CrossRef]
- Dahlström, M.; Jonsson, H.; Jonsson, P.R.; Elwing, H. Surface wettability as a determinant in the settlement of the barnacle Balanus Improvisus (DARWIN). J. Exp. Mar. Biol. Ecol. 2004, 305, 223–232. [Google Scholar] [CrossRef]
- Head, R.; Overbeke, K.; Klijnstra, J.; Biersteker, R.; Thomason, J. The Effect of Gregariousness in Cyprid Settlement Assays. Biofouling 2003, 19, 269–278. [Google Scholar] [CrossRef]
- Jonsson, P.R.; Berntsson, K.M.; Larsson, A.I. Linking larval supply to recruitment: Flow-mediated control of initial adhesion of barnacle larvae. Ecology 2004, 85, 2850–2859. [Google Scholar] [CrossRef]
- Brancato, M.S.; Woollacott, R.M. Effect of microbial films on settlement of bryozoan larvae (Bugula simplex, B. stolonifera and B. turrita). Mar. Biol. 1982, 71, 51–56. [Google Scholar] [CrossRef]
- Marshall, D.J.; Keough, M.J. Variation in the dispersal potential of non-feeding invertebrate larvae: The desperate larva hypothesis and larval size. Mar. Ecol. Prog. Ser. 2003, 255, 145–153. [Google Scholar] [CrossRef]
- Pei-Yuan, Q.; Rittschof, D.; Sreedhar, B. Macrofouling in unidirectional flow: Miniature pipes as experimental models for studying the interaction of flow and surface characteristics on the attachment of barnacle, bryozoan and polychaete larvae. Mar. Ecol. Prog. Ser. 2000, 207, 109–121. [Google Scholar]
- Hamer, J.P.; Walker, G. Avoidance of dried biofilms on slate and algal surfaces by certain spirorbid and bryozoan larvae. J. Mar. Biol. Assoc. UK 2001, 81, 167–168. [Google Scholar] [CrossRef]
- Pires, A.; Woollacott Robert, M. A Direct and Active Influence of Gravity on the Behavior of a Marine Invertebrate Larva. Science 1983, 220, 731–733. [Google Scholar] [CrossRef] [PubMed]
- Rossi, S.; Gili, J.M.; Hugues, R.G. The effects of exposure to wave action on the distribution and morphology of the epiphytic hydrozoans Clava multicornis and Dynamena pumila. Sci. Mar. 2000, 64, 135–140. [Google Scholar] [CrossRef] [Green Version]
- Maldonado, M.; Young, C.M. Effects of physical factors on larval behavior, settlement and recruitment of four tropical demosponges. Mar. Ecol. Prog. Ser. 1996, 138, 169–180. [Google Scholar] [CrossRef]
- Chia, F.; Bickell, L. Mechanisms of larval attachment and the induction of settlement and metamorphosis in coelenterates: A Review. In Settlement and Metamorphosis of Marine Invertebrate Larvae; Chia, F.-S., Rice, M.E., Eds.; Elsevier: New York, NY, USA, 1978. [Google Scholar]
- Gipperth, L. The legal design of the international and European Union ban on tributyltin antifouling paint: Direct and indirect effects. J. Environ. Manag. 2009, 90, S86–S95. [Google Scholar] [CrossRef] [PubMed]
- Natalio, F.; André, R.; Hartog, A.F.; Stoll, B.; Jochum, K.P.; Wever, R.; Tremel, W. Vanadium pentoxide nanoparticles mimic vanadium haloperoxidases and thwart biofilm formation. Nat. Nanotechnol. 2012, 7, 530–535. [Google Scholar] [CrossRef]
- Ghasemian, E.; Naghoni, A.; Rahvar, H.; Kialha, M.; Tabaraie, B. Evaluating the Effect of Copper Nanoparticles in Inhibiting Pseudomonas aeruginosa and Listeria monocytogenes Biofilm Formation. Jundishapur J. Microbiol. 2015, 8, e17430. [Google Scholar] [CrossRef] [Green Version]
- Cao, P.; Cao, Z.; Yuan, C. Stainless steel coated by Cu NPs via dopamine coupling for antifouling application. Surf. Interface Anal. 2019, 51, 809–816. [Google Scholar] [CrossRef]
- Abi Nassif, L.; Rioual, S.; Farah, W.; Fauchon, M.; Toueix, Y.; Hellio, C.; Abboud, M.; Lescop, B. Electrophoretic deposition of zinc alginate coatings on stainless steel for marine antifouling applications. J. Environ. Chem. Eng. 2020, 8, 104246. [Google Scholar] [CrossRef]
- Zhang, S.; Liang, X.; Gadd, G.M.; Zhao, Q. Advanced titanium dioxide-polytetrafluorethylene (TiO2-PTFE) nanocomposite coatings on stainless steel surfaces with antibacterial and anti-corrosion properties. Appl. Surf. Sci. 2019, 490, 231–241. [Google Scholar] [CrossRef]
- Lopes, F.S.; Oliveira, J.R.; Milani, J.; Oliveira, L.D.; Machado, J.P.B.; Trava-Airoldi, V.J.; Lobo, A.O.; Marciano, F.R. Biomineralized diamond-like carbon films with incorporated titanium dioxide nanoparticles improved bioactivity properties and reduced biofilm formation. Mater. Sci. Eng. C 2017, 81, 373–379. [Google Scholar] [CrossRef] [Green Version]
- Chen, L.; Zheng, L.; Lv, Y.; Liu, H.; Wang, G.; Ren, N.; Liu, D.; Wang, J.; Boughton, R.I. Chemical assembly of silver nanoparticles on stainless steel for antimicrobial applications. Surf. Coat. Technol. 2010, 204, 3871–3875. [Google Scholar] [CrossRef]
- Cao, P.; He, X.; Xiao, J.; Yuan, C.; Bai, X. Covalent bonding of AgNPs to 304 stainless steel by reduction in situ for antifouling applications. Appl. Surf. Sci. 2018, 452, 201–209. [Google Scholar] [CrossRef]
- Jang, Y.; Choi, W.T.; Johnson, C.T.; García, A.J.; Singh, P.M.; Breedveld, V.; Hess, D.W.; Champion, J.A. Inhibition of Bacterial Adhesion on Nanotextured Stainless Steel 316L by Electrochemical Etching. ACS Biomater. Sci. Eng. 2018, 4, 90–97. [Google Scholar] [CrossRef] [Green Version]
- Arias-Flores, R.; Rosado-Quiab, U.; Vargas-Valerio, A.; Grajales-Muñiz, C. Los microorganismos causantes de infecciones nosocomiales en el Instituto Mexicano del Seguro Social. Rev. Med. IMSS 2016, 54, 5. [Google Scholar]
- WHO—World Health Organization. WHO Publishes List of Bacteria for Which New Antibiotics Are Urgently Needed. Available online: https://www.who.int/es/news/item/27-02-2017-who-publishes-list-of-bacteria-for-which-new-antibiotics-are-urgently-needed (accessed on 1 July 2021).
- Zottola, E.A.; Sasahara, K.C. Microbial biofilms in the food processing industry—Should they be a concern? Int. J. Food Microbiol. 1994, 23, 125–148. [Google Scholar] [CrossRef]
- Le, K.Y.; Otto, M. Quorum-sensing regulation in staphylococci—An overview. Front. Microbiol. 2015, 6, 1174. [Google Scholar] [CrossRef] [Green Version]
- Almasoud, A.; Hettiarachchy, N.; Rayaprolu, S.; Babu, D.; Kwon, Y.M.; Mauromoustakos, A. Inhibitory effects of lactic and malic organic acids on autoinducer type 2 (AI-2) quorum sensing of Escherichia coli O157:H7 and Salmonella Typhimurium. LWT-Food Sci. Technol. 2016, 66, 560–564. [Google Scholar] [CrossRef] [Green Version]
- Tsai, K.-P. Effects of two copper compounds on Microcystis aeruginosa cell density, membrane integrity, and microcystin release. Ecotoxicol. Environ. Saf. 2015, 120, 428–435. [Google Scholar] [CrossRef]
- Pollard, T.D.; Earnshaw, W.C.; Lippincott-Schwartz, J.; Johnson, G. Cell Biology E-Book; Elsevier Health Sciences: Amsterdam, The Netherlands, 2016. [Google Scholar]
- Cerca, N.; Pier, G.B.; Vilanova, M.; Oliveira, R.; Azeredo, J. Quantitative analysis of adhesion and biofilm formation on hydrophilic and hydrophobic surfaces of clinical isolates of Staphylococcus epidermidis. Res. Microbiol. 2005, 156, 506–514. [Google Scholar] [CrossRef] [Green Version]
- Cunliffe, D.; Smart, C.A.; Alexander, C.; Vulfson, E.N. Bacterial Adhesion at Synthetic Surfaces. Appl. Environ. Microbiol. 1999, 65, 4995–5002. [Google Scholar] [CrossRef] [Green Version]
- Marques, S.C.; Rezende, J.d.G.O.S.; Alves, L.A.d.F.; Silva, B.C.; Alves, E.; Abreu, L.R.d.; Piccoli, R.H. Formation of biofilms by Staphylococcus aureus on stainless steel and glass surfaces and its resistance to some selected chemical sanitizers. Braz. J. Microbiol. 2007, 38, 538–543. [Google Scholar] [CrossRef] [Green Version]
- Stanić, V.; Dimitrijević, S.; Antić-Stanković, J.; Mitrić, M.; Jokić, B.; Plećaš, I.B.; Raičević, S. Synthesis, characterization and antimicrobial activity of copper and zinc-doped hydroxyapatite nanopowders. Appl. Surf. Sci. 2010, 256, 6083–6089. [Google Scholar] [CrossRef]
- McShan, D.; Ray, P.C.; Yu, H. Molecular toxicity mechanism of nanosilver. J. Food Drug Anal. 2014, 22, 116–127. [Google Scholar] [CrossRef] [Green Version]
- Sondi, I.; Salopek-Sondi, B. Silver nanoparticles as antimicrobial agent: A case study on E. coli as a model for Gram-negative bacteria. J. Colloid Interface Sci. 2004, 275, 177–182. [Google Scholar] [CrossRef] [PubMed]
- Xu, H.; Shi, X.; Ma, H.; Lv, Y.; Zhang, L.; Mao, Z. The preparation and antibacterial effects of dopa-cotton/AgNPs. Appl. Surf. Sci. 2011, 257, 6799–6803. [Google Scholar] [CrossRef]
- Innocenzi, P.; Kozuka, H. Methyltriethoxysilane-derived sol-gel coatings doped with silver metal particles. J. Sol-Gel Sci. Technol. 1994, 3, 229–233. [Google Scholar] [CrossRef]
- Miao, A.-J.; Schwehr, K.A.; Xu, C.; Zhang, S.-J.; Luo, Z.; Quigg, A.; Santschi, P.H. The algal toxicity of silver engineered nanoparticles and detoxification by exopolymeric substances. Environ. Pollut. 2009, 157, 3034–3041. [Google Scholar] [CrossRef]
- Navarro, E.; Piccapietra, F.; Wagner, B.; Marconi, F.; Kaegi, R.; Odzak, N.; Sigg, L.; Behra, R. Toxicity of Silver Nanoparticles to Chlamydomonas reinhardtii. Environ. Sci. Technol. 2008, 42, 8959–8964. [Google Scholar] [CrossRef]
- Thiel, J.; Pakstis, L.; Buzby, S.; Raffi, M.; Ni, C.; Pochan, D.J.; Shah, S.I. Antibacterial Properties of Silver-Doped Titania. Small 2007, 3, 799–803. [Google Scholar] [CrossRef]
- Feng, Q.L.; Wu, J.; Chen, G.Q.; Cui, F.Z.; Kim, T.N.; Kim, J.O. A mechanistic study of the antibacterial effect of silver ions on Escherichia coli and Staphylococcus aureus. J. Biomed. Mater. Res. 2000, 52, 662–668. [Google Scholar] [CrossRef]
- He, X.; Zhang, G.; Wang, X.; Hang, R.; Huang, X.; Qin, L.; Tang, B.; Zhang, X. Biocompatibility, corrosion resistance and antibacterial activity of TiO2/CuO coating on titanium. Ceram. Int. 2017, 43, 16185–16195. [Google Scholar] [CrossRef]
- Verdier, T.; Coutand, M.; Bertron, A.; Roques, C. Antibacterial Activity of TiO2 Photocatalyst Alone or in Coatings on E. coli: The Influence of Methodological Aspects. Coatings 2014, 4, 670–686. [Google Scholar] [CrossRef]
- Carré, G.; Hamon, E.; Ennahar, S.; Estner, M.; Lett, M.-C.; Horvatovich, P.; Gies, J.-P.; Keller, V.; Keller, N.; Andre, P.; et al. TiO2 Photocatalysis Damages Lipids and Proteins in Escherichia coli. Appl. Environ. Microbiol. 2014, 80, 2573–2581. [Google Scholar] [CrossRef] [Green Version]
- Maness, P.-C.; Smolinski, S.; Blake Daniel, M.; Huang, Z.; Wolfrum Edward, J.; Jacoby William, A. Bactericidal Activity of Photocatalytic TiO2 Reaction: Toward an Understanding of Its Killing Mechanism. Appl. Environ. Microbiol. 1999, 65, 4094–4098. [Google Scholar] [CrossRef] [Green Version]
- Ge, L.; Na, G.; Zhang, S.; Li, K.; Zhang, P.; Ren, H.; Yao, Z. New insights into the aquatic photochemistry of fluoroquinolone antibiotics: Direct photodegradation, hydroxyl-radical oxidation, and antibacterial activity changes. Sci. Total Environ. 2015, 527—528, 12–17. [Google Scholar] [CrossRef]
- Gogniat, G.; Dukan, S. TiO2 Photocatalysis Causes DNA Damage via Fenton Reaction-Generated Hydroxyl Radicals during the Recovery Period. Appl. Environ. Microbiol. 2007, 73, 7740–7743. [Google Scholar] [CrossRef] [Green Version]
- Fenoglio, I.; Ponti, J.; Alloa, E.; Ghiazza, M.; Corazzari, I.; Capomaccio, R.; Rembges, D.; Oliaro-Bosso, S.; Rossi, F. Singlet oxygen plays a key role in the toxicity and DNA damage caused by nanometric TiO2 in human keratinocytes. Nanoscale 2013, 5, 6567–6576. [Google Scholar] [CrossRef]
- Liu, C.; Zhao, Q. The CQ ratio of surface energy components influences adhesion and removal of fouling bacteria. Biofouling 2011, 27, 275–285. [Google Scholar] [CrossRef] [PubMed]
- Zhao, Q.; Liu, Y.; Wang, C. Development and evaluation of electroless Ag-PTFE composite coatings with anti-microbial and anti-corrosion properties. Appl. Surf. Sci. 2005, 252, 1620–1627. [Google Scholar] [CrossRef]
- Li, Q.; Mahendra, S.; Lyon, D.Y.; Brunet, L.; Liga, M.V.; Li, D.; Alvarez, P.J.J. Antimicrobial nanomaterials for water disinfection and microbial control: Potential applications and implications. Water Res. 2008, 42, 4591–4602. [Google Scholar] [CrossRef]
- Luting, L.; Linlin, S.; Ercan, B.; Sun, L.; Ziemer, K.S.; Webster, T.J. Understanding the Role of Polymer Surface Nanoscale Topography on Inhibiting Bacteria Adhesion and Growth. ACS Biomater. Sci. Eng. 2016, 2, 122–130. [Google Scholar] [CrossRef]
- Choi, W.T.; Oh, K.; Singh, P.M.; Breedveld, V.; Hess, D.W. Wettability control of stainless steel surfaces via evolution of intrinsic grain structures. J. Mater. Sci. 2016, 51, 5196–5206. [Google Scholar] [CrossRef]
- Michailidis, M.; Gutner-Hoch, E.; Wengier, R.; Onderwater, R.; D’Sa, R.A.; Benayahu, Y.; Semenov, A.; Vinokurov, V.; Shchukin, G. Highly Effective Functionalized Coatings with Antibacterial and Antifouling Properties. ACS Sustain. Chem. Eng. 2020, 8, 8928–8937. [Google Scholar] [CrossRef]
- Fu, Y.; Wang, W.; Zhang, L.; Vinokurov, V.; Stavitskaya, A.; Lvov, Y. Development of Marine Epoxy Coating Enhanced with Clay Nanotubes. Materials 2019, 12, 4195. [Google Scholar] [CrossRef] [Green Version]
- Lvov, Y.; Wang, W.; Zhang, L.; Fakhrullin, R. Halloysite Clay Nanotubes for Loading and Sustaines Release of Functional Compounds. Adv. Mater. 2015, 28, 1227–1250. [Google Scholar] [CrossRef] [PubMed]
- Figueiredo, J.; Loureiro, S.; Martins, R. Hazard of novel anti-fouling nanomaterials and biocides DCOIT and silver to marine organisms. J. Environ. Sci. Nano 2020, 7, 1670–1680. [Google Scholar] [CrossRef]
- Figueiredo, J.; Oliveira, T.; Ferreira, V.; Sushkova, A.; Silva, S.; Carneiro, D.; Cardoso, D.N.; Goncalves, S.F.; Maia, F.; Rocha, C.; et al. Toxicity of innovative anti-fouling nano-based solutions to marine species. J. Environ. Sci. Nano 2019, 6, 1418–1429. [Google Scholar] [CrossRef]
- Gutner-Hoch, E.; Martins, R.; Maia, F.; Oliveira, T.; Shpigel, M.; Weis, M.; Tedim, J.; Benayahu, Y. Toxicity of engineered micro- and nanomaterials with antifouling properties to the brine shrimp Artemia salina and embryonic stages of the sea urchin Paracentrotus lividus. Environ. Pollut. 2019, 250, 530–537. [Google Scholar] [CrossRef]
- Dos Santos, J.V.N.; Martins, R.; Fontes, M.K.; de Campos, B.G.; Marques do Prado e Silva, M.B.; Maia, F.; De Souza Abessa, D.M.; Perina, F.C. Can Encapsulation of the Biocide DCOIT Affect the Anti-fouling Efficacy and Toxicity on Tropicaal Bivalves? Appl. Sci. 2020, 10, 8579. [Google Scholar] [CrossRef]
- Max-Planck-Gesellschaft Zur Forderung Der Wissenschaften Ev. The Community Research and Development Information Service (CORDIS) Project 0660523: No Biofouling Surfaces, Germany, 2015–2017; Max-Planck-Gesellschaft Zur Forderung Der Wissenschaften Ev: Munich, Germany, 2017. [Google Scholar]
- Tedim, J.; Poznvak, S.K.; Kuznetsova, A.; Raps, D.; Hack, T.; Zheludkevich, M.L.; Ferreira, M.G.S. Enhancement of active corrosion protection via combination of inhibitor-loaded nanocontainers. ACS Appl. Mater. Interfaces 2010, 2, 1528–1535. [Google Scholar] [CrossRef]
- Maia, F.; Tedim, J.; Lisenkov, A.D.; Salak, A.N.; Zheludkevich, M.L. Silica nanocontainers for active corrosion protection. Nanoscale 2012, 4, 1287–1298. [Google Scholar] [CrossRef]
- Zhang, C.; Cui, F.; Zeng, G.-M.; Jiang, M.; Yang, Z.-Z.; Yu, Z.-G.; Zhu, M.-Y.; Shen, L.-Q. Quaternary ammonium compounds (QACs): A review on occurrence, fate and toxicity in the environment. Sci. Total Environ. 2015, 518-519, 352–362. [Google Scholar] [CrossRef]
- Yamada, H.M. Behaviour Occurrence and Aquatic Toxicity of New Antifouling Biocides and Preliminary Assessment of Risk to Aquatic Ecosystems. Bull. Fish. Res. Agency 2008, 21, 31–45. [Google Scholar]
- Thomas, K.V. The environmental fate and behaviour of antifouling paint booster biocides: A review. J. Bioadhesion Biofilm Res. 2001, 17, 73–86. [Google Scholar] [CrossRef]
- Buffet, P.-E.; Tankoua, O.F.; Pan, J.-F.; Behanu, D.; Herrenknecht, C.; Poirier, L.; Amiard-Triquet, C.; Amiard, J.-C.; Bérard, J.-B.; Risso, C.; et al. Behavioural and biochemical responses of two marine invertebrates Scrobicularia plana and Hediste diversicolor to copper oxide nanoparticles. Chemosphere 2011, 84, 166–174. [Google Scholar] [CrossRef] [Green Version]
- Singh, A.K. Engineered Nanoparticles: Structure, Properties and Mechanisms of Toxicity; Academic Press: Cambridge, MA, USA, 2016. [Google Scholar]
- Wegner, A.; Besseling, E.; Foekema, E.M.; Kamermans, P.; Koelmans, A.A. Effects of nanopolystyrene on the feeding behavior of the blue mussel (Mytilus edulis L.). Environ. Toxicol. Chem. 2012, 31, 2490–2497. [Google Scholar] [CrossRef]
- Poznyak, S.K.; Tedim, J.; Rodrigues, L.M.; Salak, A.N.; Zheludkevich, M.L.; Dick, L.F.P.; Ferreira, M.G.S. Novel inorganic host layered double hydroxides intercalated with guest organic inhibitors for anticorrosión applications. Appl. Mater. Interfaces 2009, 1, 2353–2362. [Google Scholar] [CrossRef] [PubMed]
- Chandler, C.J.; Segel, I.H. Mechanism of the Antimicrobial Action of Pyrithione: Effects on Membrane Transport, ATP Levels, and Protein Synthesis. Antimicrob. Agents Chemother. 1978, 14, 60–68. [Google Scholar] [CrossRef] [PubMed] [Green Version]
- Du, M.; Guo, B.; Jia, D. Newly emerging applications of halloysite nanotubes: A review. Polym. Int. 2010, 59, 574–582. [Google Scholar] [CrossRef]
- Lvov, Y.M.; Shchukin, D.G.; Möhwald, H.; Price, R.R. Halloysite Clay Nanotubes for Controlled Release of Protective Agents. ACS Nano 2008, 2, 814–820. [Google Scholar] [CrossRef] [PubMed]
- Vinokurov, V.A.; Stavitskaya, A.V.; Glotov, A.P.; Novikov, A.A.; Zolotukhina, A.V.; Kotelev, M.S.; Gushchin, P.A.; Ivanov, E.V.; Darrat, Y.; Lvov, Y.M. Nanoparticles Formed onto/into Halloysite Clay Tubules: Architectural Synthesis and Applications. Chem. Record 2018, 18, 858–867. [Google Scholar] [CrossRef]
- Vinokurov, V.A.; Stavitskaya, A.V.; Chudakov, Y.A.; Ivanov, E.V.; Shrestha, L.K.; Ariga, K.; Darrat, Y.A.; Lvov, Y.M. Formation of Metal Clusters in Halloysite Clay Nanotubes. Sci. Technol. Adv. Mater. 2017, 18, 147–151. [Google Scholar] [CrossRef] [PubMed]
- Tashiro, T. Antibacterial and Bacterium Adsorbing Macromolecules. Macromol. Mater. Eng. 2001, 286, 63–87. [Google Scholar] [CrossRef]
- Kaczerewska, O.; Sousa, I.; Martins, R.; Figueiredo, J.; Loureiro, S.; Tedim, J. Gemini Surfactant as a Template Agent for the Synthesis of More Eco-Friendly Silica Nanocapsules. Appl. Sci. 2020, 10, 8085. [Google Scholar] [CrossRef]

| Macro Fouling Species | Description | Reference |
|---|---|---|
| Crustacean Balanus amphitrite Semibalanus balanoides Balanus improvises | Barnacles are common and are particularly difficult to remove. They respond in complex ways to a variety of signals, particularly the quorum signals of their species. Balanus improvisus tends to prefer hydrophobic metal surfaces and relatively low flow velocities. Balanus amphitrite prefers hydrophilic surfaces and prefers to settle on surfaces exposed to flows of medium velocity. | [71,72,73,74] |
| Bryozoa Bugula simplex Bugula stolonifera Bugula turrita Bugula neritina Bugula flabellata | They tend to settle on substrates with mature biofilms; however, biofilms inhibit the settlement of Bugula flabellata. | [75,76,77] |
| Tunicates or urochordates Diplosoma listerianum Didemnum candidum Ascidia mentula Ciona intestinalis | Settlement of some tunicates is facilitated or attracted by biofilms and generally increases as biofilms age. | [76] |
| Cnidarians Clava multicornis Porites astreoides Balanophyllia elegans Alcyonium siderium Dynamena pumila | Their ideal place of settlement is often in algae already settled on the material, where there is less sediment, in the bottom part of the algae. | [78,79,80] |
| Annelids Spirorbis spirorbis Spirorbis tridentatus Pomatoceros lamarckii Hydroides elegans | They tend to settle in large amounts on the surface of the material at low tide, once the biofilm has dried. | [78] |
| Sponges or beads Reneira Cliona celata | Sponge larvae do not feed. They are ephemeral and have limited dispersal. Since sponges lack adhesive glands, to adhere to a surface their ectodermal cells secrete adhesive. | [81] |
| Molluscs Dreissena polymorpha Mytilus edulis | Molluscs, unlike other organisms, are able to metamorphose in other places and move towards the material. The blue mussel, Mytilus edulis, prefers rough biofilms and hydrophobic surfaces for settlement. | [82] |
| Type of Stainless Steel | Inhibited Bacteria | Inhibited Algae | Suggested Treatment | Work Environment | Reference |
|---|---|---|---|---|---|
| Not specified | GR + Staphylacococcus aureus GR − Escherichia coli | - | Vanadium pentoxide (V2O5) particles | Marine | [84] |
| Not specified | GR + Listeria monocytogenes GR − Pseudomonas aeruginosa | - | Copper particles | Food and medicine | [85] |
| SS 304 | GR + Staphylacococcus aureus GR − Escherichia coli | Phaeodactylum triconutum | Copper particles (Polidopamide matrix) | Marine | [86] |
| SS 316L | GR − Halomonas aquamarina GR − Vibro aesturianus GR - Pseudoalteromonas elyakovii | Halamphora coffeaeformis Cylindrotheca closterium | Zinc particles (Calcium alginate matrix) | Marine | [87] |
| Not specified | GR − Pseudomonas aeruginosa GR + Staphylocuccus aureus GR − Escherichia coli | - | Anatase particles (TiO2 − Ag) | Medicine | [13] |
| SS 316L | GR − Escherichia coli GR + Staphylococcus aureus | - | TiO2-PTFE (Polytetrafluoroethylene) | Medicine | [88] |
| SS 304 | GR + Staphylocuccus aureus | - | TiO2-CID (Diamond-like carbon) | Medicine | [89] |
| SS 304 | GR − Escherichia coli | - | Ag-APTES (3-aminopropyl triethoxysilane) | Food | [90] |
| SS 304 | GR − Escherichia coli GR + Staphylococcus aureus | Chlorella pyrenoidosa Phaeodactylum tricornutum Naviculaceae spp. | Silver nanoparticles in a polidopamine matrix | Marine | [91] |
| SS 304 | GR − Escherichia coli GR − Flavobacterium sp. GR − Pseudomonas aeruginosa GR − Aeromonas sp. GR − Vibrio cholerae GR − Salmonella sp. GR − Shigella sp. GR − Enterobacter aerogenes GR − Klebsiella sp. GR − Chromohalobacter GR + Bacillus sp. GR + Micrococcus sp. GR + Corynebacterium sp. GR + Bacillus litoralis GR + Staphylococcus aureus | - | Silver particles—algae turbine ornate | Marine | [44] |
| SS 316L | GR + Staphylococcus aureus GR − Escherichia coli | - | Generation of nanotextures | Food and medicine | [92] |
Publisher’s Note: MDPI stays neutral with regard to jurisdictional claims in published maps and institutional affiliations. |
© 2022 by the authors. Licensee MDPI, Basel, Switzerland. This article is an open access article distributed under the terms and conditions of the Creative Commons Attribution (CC BY) license (https://creativecommons.org/licenses/by/4.0/).
Share and Cite
Pérez, H.; Vargas, G.; Silva, R. Use of Nanotechnology to Mitigate Biofouling in Stainless Steel Devices Used in Food Processing, Healthcare, and Marine Environments. Toxics 2022, 10, 35. https://doi.org/10.3390/toxics10010035
Pérez H, Vargas G, Silva R. Use of Nanotechnology to Mitigate Biofouling in Stainless Steel Devices Used in Food Processing, Healthcare, and Marine Environments. Toxics. 2022; 10(1):35. https://doi.org/10.3390/toxics10010035
Chicago/Turabian StylePérez, Hugo, Gregorio Vargas, and Rodolfo Silva. 2022. "Use of Nanotechnology to Mitigate Biofouling in Stainless Steel Devices Used in Food Processing, Healthcare, and Marine Environments" Toxics 10, no. 1: 35. https://doi.org/10.3390/toxics10010035
APA StylePérez, H., Vargas, G., & Silva, R. (2022). Use of Nanotechnology to Mitigate Biofouling in Stainless Steel Devices Used in Food Processing, Healthcare, and Marine Environments. Toxics, 10(1), 35. https://doi.org/10.3390/toxics10010035

